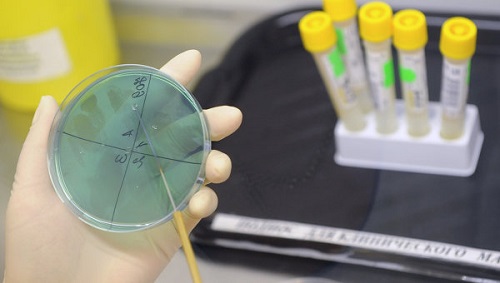
Анализ на тестостерон 529

Значение тестостерона в жизни мужчины трудно переоценить. Активно участвуя в физиологических процессах, этот гормон оказывает качественное влияние как на самочувствие, так и на и сексуальные возможности своего обладателя. Что же представляет собой тестостерон у мужчин, каковы его нормальные показатели — и насколько решаема проблема гормонального дефицита?
Главные функции тестостерона
Известный мужской гормон присутствует в организме представителей обоих полов. У мужчин его выработка осуществляется яичками и частично — надпочечниками. Именно от латинского слова «testicula», что в переводе означает «яичко», и происходит его название.
Основная роль этого гормона заключается в выполнении им двух важных функций:
- Стимуляция роста мышечной массы, сжигание жира и поддержание оптимальной плотности костных тканей. Являясь по своей химической структуре анаболическим стероидом, он активизирует образование и обновление клеток и мышечных структур.
- Формирование у мужчины вторичных половых признаков, обеспечение полноценной деятельности органов половой системы. Этому способствуют андрогенные свойства тестостерона.
Врачи подчеркивают важность тестостерона для мужского организма, отмечая его ключевую роль в поддержании физического и психического здоровья. Этот гормон отвечает за развитие половых признаков, поддержание мышечной массы и плотности костей. Кроме того, тестостерон влияет на уровень энергии, настроение и либидо. С возрастом уровень тестостерона может снижаться, что приводит к различным проблемам, таким как усталость, депрессия и снижение половой функции. Врачи рекомендуют регулярные обследования для контроля уровня гормона, особенно у мужчин старше 40 лет. Поддержание оптимального уровня тестостерона может значительно улучшить качество жизни и общее самочувствие.

Состав «мужского» гормона
В медицине существует понятие общего тестостерона, что представляет собой суммированный итог количества гормона в несвязанном (свободном) и связанном состоянии. Первая часть составляет 2%, а вторая — 98% от общего итога; при этом 44% из 98% составляет гормон, связанный с глобулином (ГСПГ), а 54% — тестостерон, связанный с белками, в т.ч. — с альбуминами. Биологически активными являются связанный с глобулином и свободный гормоны; ГСПГ же, напротив, препятствует их действию в организме.
За качество либидо и своевременное развитие у мужчин вторичных половых признаков отвечает свободный тестостерон; его недостаток может вести к импотенции.
Уровневые нормы гормона зависят от индивидуальных особенностей каждого мужчины и могут варьироваться в широком диапазоне. Предельные показатели для общего тестостерона выражаются следующими цифрами:
- возрастная категория 18-69 лет: 250-1100 нг/дл;
- мужчины 70 лет и старше: 90-890 нг/дл.
Нормальный уровень свободного тестостерона ограничен пределами:
- 46-224 нг/дл — для возрастной категории 18-69 лет;
- 6-73 нг/дл — для категории мужчин от 70 лет.
Недостаток тестостерона у мужчины: основные симптомы
Дефицит основного мужского гормона обозначается термином «гипогонадизм». Различают два вида этой патологии:
- первичный гипогонадизм (недостаточная выработка тестостерона яичками);
- вторичный гипогонадизм (сниженное продуцирование гипофизом гормонов, активизирующих в яичках синтез тестостерона).
О недостатке полового гормона в организме может свидетельствовать единичная или комплексная симптоматика:
- ожирение, преимущественно в области живота;
- усиленное потоотделение;
- снижение веса и работоспособности;
- снижение костной плотности;
- мышечная слабость;
- дряблость и сухость кожи;
- рассеянность, бессонница, раздражительность;
- приливы крови к лицу, часто возникающее чувство жара;
- систематическое возникновение покраснений в области лица и (или) груди;
- анемия;
- уменьшение роста волос или их поредение на лице и теле;
- рост грудных желез;
- снижение выраженности или интенсивности ночных эрекций;
- частичное или полное проявление импотенции;
- понижение либидо;
- бесплодие.
Существенный недостаток полового гормона в мужском организме может привести к ухудшению его общего самочувствия, проявлениям хронической усталости и серьезным депрессивным состояниям, вплоть до полной утраты интереса к жизни.

Тестостерон — это ключевой гормон, который играет важную роль в жизни мужчин. Многие люди отмечают, что уровень тестостерона влияет не только на физическую силу и выносливость, но и на эмоциональное состояние. Мужчины с нормальным уровнем этого гормона чаще чувствуют себя уверенными и энергичными. Однако, с возрастом или под воздействием стресса, уровень тестостерона может снижаться, что приводит к усталости, снижению либидо и даже депрессии.
Некоторые эксперты подчеркивают важность поддержания здорового образа жизни для оптимизации уровня тестостерона. Правильное питание, регулярные физические нагрузки и достаточный сон могут значительно улучшить гормональный баланс. В то же время, существует мнение, что чрезмерное увлечение добавками с тестостероном может быть опасным и привести к нежелательным последствиям. Важно помнить, что здоровье — это комплексный процесс, и тестостерон — лишь одна из его составляющих.
Причины возникновения дефицита гормона
Специалисты связывают снижение уровня тестостерона со следующими факторами:
- Психологический. Состояние стресса провоцирует усиленную выработку организмом адреналина, который подавляет гормональный синтез;
- Возрастной. Даже у здоровых мужчин после 30 лет отмечается ежегодное понижение уровня полового гормона на 1-1,5%;
- «Вредный» рацион питания. Систематическое употребление продуктов с избыточным содержанием холестерина, увлечение алкоголем или шипучими напитками, а также избыточное потребление соли, сахара и кофеина напрямую отражаются на продуцировании организмом тестостерона;
- Малоактивный образ жизни;
- Травмы половых органов;
- Употребление анаболических стероидов;
- Побочные эффекты от приема лекарств или последствия перенесенных заболеваний.
Хронические болезни и их влияние на уровень тестостерона
На сегодняшний день установлена взаимосвязь гипогонадизма с рядом предшествовавших его возникновению заболеваний:
- сахарный диабет;
- ишемическая болезнь сердца;
- атеросклероз;
- ожирение;
- артериальная гипертония;
- бронхиальная астма;
- туберкулез;
- цирроз печени;
- алкоголизм;
- ВИЧ и СПИД.
Негативное влияние хронических болезней происходит не обязательно посредством их прямого воздействия на половую сферу. Снижение данного гормона может быть вызвано нарушениями в работе пострадавших в результате заболеваний гипофиза или гипоталамуса.
Повышенный уровень тестостерона: опасно ли это для мужского организма?
Тестостерон у мужчин в своей норме имеет ограничения как для минимальных, так и для максимальных показателей. Избыток гормона может привести к заболеваниям или патологиям разной степени тяжести:
- Акне. Повышенное количество тестостерона активизирует работу сальных желез, что влечет за собой излишнюю выработку кожного сала;
- Резкие перепады настроения, частичная утрата инстинкта самосохранения, повышенная агрессия.
- Сердечные приступы. Существенное превышение уровня тестостерона значительно увеличивает риск возникновения болезней сердца и сосудов;
- Апноэ сна. Непроизвольное прекращение дыхания во время сна может длиться от 10 секунд до 2-3 минут. Апноэ, в свою очередь, может явиться причиной артериальной или легочной гипертензии, а в некоторых случаях — привести мужчину к инсульту;
- Болезни печени. Основной причиной их возникновения служит неконтролируемый прием мужчиной анаболических стероидов, в целях повышения уровня тестостерона;
- Облысение. Доказано, что ранняя утрата волос напрямую связана с избытком в организме мужского гормона;
- Рак простаты. Медицинские исследования подтвердили взаимосвязь между патологическими изменениями предстательной железы и высоким уровнем тестостерона в организме мужчины;
- Бесплодие. Избыток гормона провоцирует рост количества эритроцитов и ведет к снижению количества сперматозоидов.
Анализ на тестостерон
Тестостерон у мужчин рекомендуется проверять в следующих случаях:
- бесплодие;
- снижение или отсутствие полового влечения;
- нарушения половых функций (мужской климакс, снижение потенции и т.д.);
- ожирение;
- облысение;
- угревая сыпь;
- остеопороз;
- хронический простатит;
- опухоли яичек;
- хромосомные заболевания;
- недостаточность функций гипофиза;
- снижение уровня белка ГСПГ;
- определение первичного или вторичного гипогонадизма.
Анализ крови на тестостерон осуществляется в клинических условиях посредством венепункции. Уровень гормона зависит от времени суток (утром показатели выше, нежели в вечернее время), а также от сезонного фактора (осенью у мужчин отмечается повышение уровня тестостерона).
На результаты анализа могут также влиять:
- Голодание;
- Вегетарианская диета;
- Повышение температуры тела;
- Прием гормонов или барбитуратов. В таких случаях наблюдается повышение тестостерона;
- Употребление сердечных гликозидов, нейролептиков, диуретиков и алкоголя. Содержание мужского гормона при этом понижается.
Для получения максимально объективной картины исследования кровь на анализ должна сдаваться натощак. За час до прохождения теста мужчине рекомендуется начать придерживаться ряда рекомендаций:
- воздержаться от курения;
- избегать стрессовых ситуаций;
- отказаться от приема лекарственных препаратов и продуктов, влияющих на показатели тестостерона;
- исключить любые физические нагрузки на организм.
Результаты тестирования
Норма у взрослого мужчины должна составлять 2,6 – 11нг/мл.
Повышенные показатели гормона могут служить косвенными признаками заболеваний или нарушений в работе организма:
- снижение уровня ГСПГ;
- экстрагонадные (развивающиеся из сперматозоидов) опухоли;
- болезнь Иценко-Кушинга;
- раннее половое созревание у мальчиков;
- гиперплазия надпочечников;
- опухоли коры надпочечников.
Недостаточный уровень обычно наблюдается при наличии одной или нескольких патологий, в числе которых:
- замедление полового созревания;
- миотоническая дистрофия;
- первичный либо вторичный гипогонадизм;
- крипторхизм;
- уремия;
- синдром Кальмана;
- синдром Клайнфельтера;
- недостаточная функция половых желез;
- почечная или печеночная недостаточность;
- хронический простатит;
- ожирение;
- синдром Дауна.
Для нормализации тестостерона мужчине необходимо пройти назначенный врачом курс терапии, во время которого пациенту рекомендуется:
- отказаться от вредных для организма привычек;
- не употреблять анаболические стероиды;
- придерживаться здорового рациона питания;
- изменить малоподвижный образ жизни на активный;
- не пренебрегать полноценным отдыхом.

Будьте внимательны к своему здоровью, и организм отблагодарит вас за это отличным мужским самочувствием!
Вопрос-ответ
Как влияет тестостерон на мужской организм?
Тестостерон у мужчин вырабатывается железами половых органов, расположенными в яичках. Под его действием усиливается развитие органов половой системы и вторичных половых признаков. Он стимулирует производство спермы, а также отвечает за сексуальное влечение. Гормон помогает нарастить мышечную и костную массу.
Что происходит у мужчин при нехватке тестостерона?
Снижение силы мышц, нарушение репродуктивной функции, частые переломы, инсулинорезистентность, сахарный диабет 2-го типа.
Как ведёт себя мужчина с высоким тестостероном?
Мужчины с высоким уровнем тестостерона стремятся брать инициативу в свои руки, подчинять своей воле других. Они решительно выражают свое мнение и гнев, весьма энергичны и более удачливы. Тестостерон важен для развития вторичных половых признаков и осуществления мужчинами половой функции.
Какой самый важный гормон у мужчин?
Тестостерон синтезируется как у мужчин, так и у женщин, но его влияние особенно заметно в мужском организме. Он отвечает за: половое созревание — формирование вторичных половых признаков. Фертильность — поддержание репродуктивной функции.
Советы
СОВЕТ №1
Следите за уровнем тестостерона: Регулярные медицинские обследования помогут вам контролировать уровень тестостерона в организме. Если вы заметили симптомы, такие как усталость, снижение либидо или изменения в настроении, обратитесь к врачу для анализа.
СОВЕТ №2
Поддерживайте здоровый образ жизни: Правильное питание, регулярные физические нагрузки и достаточный сон способствуют поддержанию нормального уровня тестостерона. Включите в свой рацион продукты, богатые цинком и витамином D, такие как орехи, рыба и яйца.
СОВЕТ №3
Избегайте стрессов: Хронический стресс может негативно сказаться на уровне тестостерона. Практикуйте методы релаксации, такие как медитация, йога или просто прогулки на свежем воздухе, чтобы снизить уровень стресса и улучшить общее самочувствие.
СОВЕТ №4
Ограничьте потребление алкоголя и табака: Избыточное употребление алкоголя и курение могут негативно влиять на уровень тестостерона. Постарайтесь сократить или полностью исключить эти привычки для поддержания здоровья и гормонального баланса.